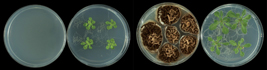

|
A la izquierda, plantas-control cultivadas en ausencia de compuestos
volátiles microbianos. A la derecha, plantas crecidas en presencia de
compuestos volátiles emitidos por un hongo fitopatógeno. / CSIC
|
Los microorganismos fitopatógenos emiten compuestos que fomentan el
crecimiento de las plantas.
Investigadores del CSIC demuestran que una amplia gama de
microorganismos nocivos para las plantas producen compuestos volátiles
bioestimulantes. El hallazgo podría aplicarse en la mejora de los
rendimientos de los cultivos de manera sostenible.
Una amplia gama de microorganismos, incluyendo hongos y bacterias
fitopatógenos, son capaces de emitir compuestos volátiles que fomentan
el crecimiento de las plantas, la floración y la acumulación de
sustancias de reserva, según ha demostrado un estudio dirigido por
investigadores del Instituto de Agrobiotecnología de Navarra (centro
mixto del Consejo Superior de Investigaciones Científicas, la
Universidad Pública de Navarra y el Gobierno de Navarra).
El hallazgo podría aplicarse en la mejora de los rendimientos de los
cultivos de manera sostenible y como una alternativa a los tratamientos
agroquímicos convencionales y al fomento de la interacción entre plantas
y un reducido número de cepas de microorganismos beneficiosos. Los
resultados se publican dos artículos en las revistas Plant Cell and
Environment y Plant Physiology.
“Este estudio propone por primera vez el concepto de Bad little
critters, beneficial workers, según el cual los microorganismos no
beneficiosos constituyen una inexplorada y prometedora cantera de
sustancias bioestimulantes de elevado potencial biotecnológico”, explica
Javier Pozueta, investigador del CSIC en el Instituto de
Agrobiotecnología.
Los artículos recogen además los resultados de los estudios realizados
sobre los mecanismos bioquímicos y moleculares implicados en la
respuesta “positiva” de las plantas a compuestos volátiles emitidos por
microorganismos que, desde un punto de vista antropocéntrico, son
considerados como “negativos” o “no beneficiosos”.
Tales estudios demuestran que los compuestos microbianos ejercen un
efecto positivo sobre la capacidad de la planta de convertir el CO2 del
aire en biomasa. El trabajo es consistente con la idea de que los
organismos están relacionados o comunicados entre sí a través de
infoquímicos o sustancias mensajeras.
El hallazgo supone una provechosa vía de estudio ante la demanda
creciente de alimentos surgida como consecuencia del incremento de la
población mundial, así como la progresiva reducción de las superficies
cultivables.
El trabajo ha sido realizado en colaboración con investigadores del
Centre of the Region Haná for Biotechnological and Agricultural Research
de la Universidad de Palacký (República Checa) dentro del marco de
colaboración del proyecto internacional I-LINK 0939 del programa
i-LINK+, financiado por el CSIC, para la promoción de la colaboración
científica internacional.
Fuente: Instituto de Agrobiotecnología de Navarra/CSIC 22/11/2016
Ángela María Sánchez-López, Marouane Baslam, Nuria De Diego,
Francisco José Muñoz, Abdellatif Bahaji, Goizeder Almagro, Adriana
Ricarte-Bermejo, Pablo García-Gómez, Jun Li, Jan F. Humplík, Ondřej
Novák, Lukáš Spíchal, Karel Doležal, Edurne Baroja-Fernández & Javier
Pozueta-Romero. Volatile compounds emitted by diverse phytopathogenic
microorganisms promote plant growth and flowering through cytokinin
action. Plant Cell and Environment. Doi: 10.1111/pce.12759
Sánchez-López, A.M., Bahaji, A., De Diego, N., Baslam, M., Li, J.,
Muñoz, F.J., Almagro, G., García-Gómez, P, Ameztoy, K., Ricarte-Bermejo,
A., Novák, O, Humplík, J.F., Spíchal, L., Doležal, K., Ciordia, S., Mena,
M.C., Baroja-Fernández, E., Pozueta-Romero, J. Arabidopsis responds to
Alternaria alternata volatiles by triggering plastid phosphoglucose
isomerase-independent mechanisms. Plant Physiology. Doi:
10.1104/pp.16.00945.
www.cci-calidad.com |